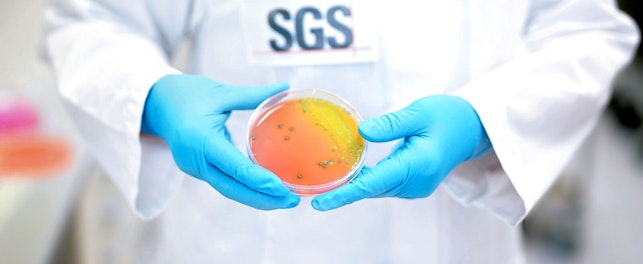
SGS Microbiology Services Lab Scientist Holding Specimen

We are pleased to announce the release of our latest white paper, 'Skin longevity: from ancient wisdom to modern clinical evaluation,' which explores how cutting-edge, non-invasive clinical tools are advancing our understanding of skin health and aging.
Humanity's quest for youthful, resilient skin stretches back thousands of years, from the natural oils and herbal remedies used by ancient civilizations to the evidence-based approaches of today. Modern science now recognizes skin longevity as more than just aesthetics. It encompasses the preservation of physiological integrity over time, supported by objective biomarkers and validated clinical endpoints.
Our new white paper examines the biological drivers of skin aging and details how advanced, non-invasive techniques are transforming clinical evaluation. By combining imaging, biomechanical assessment, biomarker analysis and hydration and barrier function measurements, researchers can now generate multi-dimensional data to scientifically substantiate product claims.
Download the white paper to learn about:
- Key mechanisms of skin aging
- Non-invasive tools for assessing skin longevity
- Integrated frameworks that combine visual, functional and molecular insights
- Future directions in omics technology and standardized clinical protocols
The white paper will be of particular interest to researchers, clinicians and product developers seeking to develop skincare solutions that extend skin vitality and delay the visible signs of aging.
Download the white paper: Skin Longevity: From Ancient Wisdom to Modern Clinical Evaluation
For further information, please contact:
Jennifer Buckley
Senior Global Marketing Manager, Health & Nutrition
t: +1 973 461 1498
About SGS
SGS is the world’s leading Testing, Inspection and Certification company. We operate a network of over 2,500 laboratories and business facilities across 115 countries, supported by a team of 99,500 dedicated professionals. With over 145 years of service excellence, we combine the precision and accuracy that define Swiss companies to help organizations achieve the highest standards of quality, compliance and sustainability.
Our brand promise – when you need to be sure – underscores our commitment to trust, integrity and reliability, enabling businesses to thrive with confidence. We proudly deliver our expert services through the SGS name and trusted specialized brands, including Brightsight, Bluesign, Maine Pointe and Nutrasource.
SGS is publicly traded on the SIX Swiss Exchange under the ticker symbol SGSN (ISIN CH1256740924, Reuters SGSN.S, Bloomberg SGSN:SW).